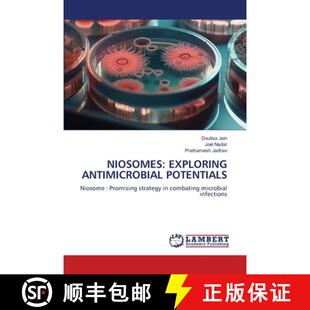

Electrode 4周达 Potentials 2nd 9780198883579 Edition
¥697697售0件

Hippocampus Sources Mechanisms Extracellular Biophysical 4周达 9783319410388 Potentials and the
¥11821182售0件

Potentials Domain Retarded Road 9783319799865 and 4周达 Integral Boundary Time Map Equations
¥11821182售0件

Business 4周达 Management Risk with the Potentials Precautionary Loss Catastrophic 9780230013520 ... Dealing
¥11821182售0件

and Potentials Globalization the 9781475776461 Children 4周达 Enhancing for Exploring Lives... Opportunities
¥11821182售0件

Potentials 4周达 Evoked 9781468490091 Advanced
¥11821182售0件

Inert 9783642822230 Crystals Energy 4周达 Transfer Potentials Gases Doped Dynamics and
¥11821182售0件

Tohoku Recovery Future 9784431563730 and 4周达 Potentials Challenges
¥11821182售0件

Pharmocology 4周达 Cord Spinal Physiology and Evoked Guide illustrated 9784431563129 Reco... Potentials
¥11821182售0件

Tohoku Recovery Future 9784431551355 and 4周达 Potentials Challenges
¥11821182售0件

and Potentials Globalization the 9780306473685 Children 4周达 Enhancing for Exploring Lives... Opportunities
¥11821182售0件

Ecological Diversity Potentials Systems Disregarded Aquatic 4周达 9789400735347 Microbial and
¥11821182售0件

Functionals Theory and The... Density Potentials 4周达 9783662148341 Functional Effective
¥11821182售0件

Potentials Report Biotechnology 9783642705373 Workshop and 4周达 the Limitations Biotechnology... Dahlem
¥11821182售0件

Ecological Diversity Potentials Systems Disregarded Aquatic 4周达 9789400711976 Microbial and
¥11821182售0件

Limits 4周达 and Technology Policy Potentials Future Science the for 9783642440410 Foresi... Innovation
¥11821182售0件

Agroforestry Realities Possibilities Potentials 4周达 and 9789024735907
¥23342334售0件

The Bereitschaftspotential Potentials 9781461349587 Cortical 4周达 Related Movement
¥23342334售0件

Identification 9781071628294 4周达 Potentials Bioactive and Isolation Microbes Endophytic
¥14551455售0件

Ecological 4周达 Interactions Nature the Social Systems Human Potentials Anthropocene 9780415510004 Ana...
¥21222122售0件

Phytochemical Potentials for Applications 4周达 Dermatological 9781032491134
¥26982698售0件
Niosomes 3周达 Exploring Antimicrobial 9786207844012 Potentials
¥576576售0件

Perspectives 9780470516492 4周达 Wiley电子电气工程 Potentials And Networks Generation Next
¥11521152售0件

African Potentials Lifeness 9789956552306 and 3周达 Incompleteness Bricolage
¥12431243售0件

Challenges 9789811602849 Media Risk Reduction Disaster 4周达 and Potentials Advances
¥16981698售0件

the 9780306478581 4周达 Nanotechnology Potentials Unleashing Lithography Alternative
¥16981698售0件

the 9781461348368 4周达 Nanotechnology Potentials Unleashing Lithography Alternative
¥16981698售0件

Countries Its Potentials Urban and 4周达 9781512811919 Renewal Emergence European
¥971971售0件

Chemical profile 9786202673303 Ocimum potentials basilicum biological 预订 and
¥698698售0件

Resources 9780837184913 4周达 Potentials and Production Energy Power Soviet
¥698698售0件